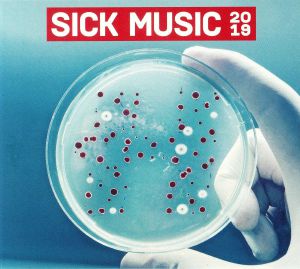

hospital
SICK MUSIC 2019 (Hospital CD)
SICK MUSIC 2019 (Hospital CD)
Couldn't load pickup availability
tracks
cd 1: fred v - burning me / degs - poveglia (feat. de:tune) (whiney remix) / london elektricity - funkopolis / s.p.y - dusty fingers (feat. diane charlemagne)
(metrik remix) / john holt - police in helicopter (benny l remix) / inja x whiney - be my cure / makoto x hugh hardie - bluebird / bou x unglued - ascendant man
/ flava d - return to me / mitekiss - lie awake (feat. degs) / lakeway - war dub / grafix – frozen
cd 2: logistics - levitate / mrsa - nail out / krakota - reload / gridlok - it’s not techno / anile - allergens (bop remix) / impish - hive / polaris - alignment / pete
cannon - ella / murdock - headshot / in:most x saikon - untold history / zephire - desperation (primate remix) / dip vertigo & dr. apollo - red (feat. josh phillips)
/ walk:r – solis
cd 3: sick music 2019 continuous mix (original)
NHS 345 CD
Share